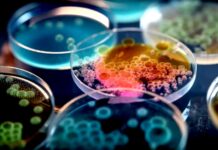
Monitoring odpadních vod efektivně chrání veřejné zdraví odpadnich_vod

Orangutan Rakus doktory nepotřebuje. Rány si sám léčí bylinami
Orangutan sumaterský žijící ve volné přírodě si sám léčil hlubokou ránu na tváři silicí z byliny s protizánětlivými účinky. Do tří dnů se rána zacelila. Rostlinu rovněž žvýkal a několik týdnů i více odpočíval.
Pobočku ÚOCHB v Bostonu povede kontroverzní David Sabatini
První laboratoř Ústavu organické chemie a biochemie [ÚOCHB] v americkém Bostonu povede americký biolog David M. Sabatini. Ten je od loňského října zaměstnancem českého ÚOCHB.
Farmaceuti v Hradci Králové rozjeli OncoPharm za 75 milionů
Farmaceutická fakulta UK v Hradci Králové zahájila práci na projektu Předaplikační výzkum léčiv pro onkologická onemocnění a pro prevenci a léčbu jimi navozených závažných komplikací. Projekt nese zkratku OncoPharm.
Farmaceuti v Hradci Králové zahájili projekt NETPHARM za 495,5 mil. Kč
Na inovace ve farmacii se zaměří ve čtyřletém projektu NETPHARM s rozpočtem půl miliardy korun vědečtí pracovníci Farmaceutické fakulty UK v Hradci Králové. Výzkum se soustředí na technologii výroby, podávání léků i lékové interakce.
Jsou to informace, které mění naše vědomí, říká Richard Papík
„Já osobně mám takový rituál, na který mám vyhrazené páteční odpoledne až podvečer, kdy si chodím studovat do některých knihoven, protože miluji atmosféru té studovny,“ říká v rozhovoru doc. PhDr. Richard Papík, Ph.D.
Český lékař David Lauer uspěl na prestižní Harvard Medical School
Devětadvacetiletý David Lauer, postgraduální student 3. LF UK, úspěšně zakončil jako první český lékař roční postgraduální hybridní studijní program „Clinical Science Scholars Program“ na Harvard Medical School a Semmelweis University.
Vědci ÚFCH JH pracují na „zkapalnění“ metanu či vodíku
Katalyzátor měnící metan na metanol vyvíjí nová spin-off společnost Ústavu fyzikální chemie J. Heyrovského AV ČR. Ředitel Ústavu Martin Hof již podepsal dohodu se společností Mettoc, SE o majetkovém vstupu do firmy.
Nádory ledvin jsem se učil operovat třikrát, říká profesor Babjuk
Rakovina prostaty spíš postihne lidi aktivní a v dobré fyzické kondici. Naopak lidé s nádory měchýře jsou z opačného spektra společnosti. Byť to neplatí absolutně, praxe to ukazuje. V obsáhlém rozhovoru to říká onkourolog prof. Marek Babjuk.
Genomička Markéta Tomková získala Cenu Czexpats in Science
Česká genomička Markéta Tomková, která působí na Oxfordské univerzitě, získala Cenu Czexpats in Science. Ocenění míří na české vědkyně a vědce v zahraničí, kteří ale i udržují profesní a osobní vazby s Českou republikou.
Riziko Alzheimerovy nemoci zvyšuje neléčená hypertenze
Riziko Alzheimerovy nemoci zvyšuje neléčený či špatně léčený vysoký krevní tlak už ve středním věku. Upozornil na to přednosta Neurologické kliniky 3. LF UK a Fakultní Thomayerovy nemocnice profesor Robert Rusina.
Němečtí vědci testují inovativní přístroj na ozařování od české firmy
Němečtí vědci testují přístroj české firmy, který by lépe zacílil ozařování při léčbě nádorů uvnitř hlavy a přispěl k prevenci jejich rozšíření a návratu. Vědci si od nové technologie slibují lepší poznání, jak často a kde se mění umístění nádoru.
Vědci uspěli při izolaci léčivých triterpenů z přírodních zdrojů
Tým českých vědců po čtyřleté práci přišel na to, jak izolovat triterpeny z přírodních zdrojů, jako jsou například slupky jablek, nať rozmarýnu či játra žraloků. Smyslem objevu je využití triterpenů pro léčivé účinné látky.
Léčbu následků sepse i s pomocí AI prozkoumají vědci z ICRC
Na výzkum otravy krve neboli sepse získali vědci Mezinárodního centra klinického výzkumu v Brně 6,9 milionu eur [cca 180 mil. Kč]. Vyvinout chtějí i nástroj umělé inteligence, který předpoví následky po otravě a určí vhodnou léčbu.
Je čas myslet na udržitelné stravování, říká Lenka Fryčová
„Současná živočišná produkce se zvrhla,” říká pro Zdravé Zprávy Lenka Fryčová ze Světového fondu na ochranu přírody. Téměř dvě třetiny roční spotřeby obilovin v EU jdou na výkrm zvířat, říká s tím, že je načase myslet i na udržitelné stravování.
Chraňte svou střevní výstelku. Nepijte alkohol!
Sklenice piva nebo vína oběd zpříjemní a přispěje i k dobré náladě. Co ale alkohol udělá s triliony mikrobů, které obývají naše vnitřnosti? Vědci nezjistili nic nového, když tvrdí, že mikrobům v našich střevech škodí nadměrné pití alkoholu.
Monitoring odpadních vod efektivně chrání veřejné zdraví
Když se Warish Ahmed vydal na dráhu mikrobiologa, určitě si nepředstavoval, že jeho hlavní pracovní náplní bude rozbor litrů odpadních vod z kanalizace v Quennslandu v Austrálii. Přesto je se svou prací spokojený a dělá ji rád.
Vědci ÚOCHB urychlují rozpouštění implantátů v lidském těle
Vědci z Ústavu organické chemie a biochemie AV ČR [ÚOCHB] ve spolupráci s univerzitou v belgickém Gentu zkoumají vlastnosti materiálů na bázi želatiny užívaných ve zdravotnictví. Nyní přišli s možností jejich sledování na přístrojích.
Na toxiny v těle českých dětí a dospělých si nyní posvítí SZÚ
Zdraví škodlivé látky v těle českých dětí a dospělých sledují od letoška pracovníci Centra zdraví a životního prostředí Státního zdravotního ústavu [SZÚ]. Rozbory vzorků moče a vlasů ukáží na toxiny jako bisfenoly, ftaláty, pesticidy i těžké kovy.
Národní ústav pro výzkum rakoviny rekapituloval loňský rok
Národní ústav pro výzkum rakoviny [NÚVR] shrnul, co dělal loni. A představil plány pro letošek. Již nyní připravuje i projekty se zaměřením na onkologii pro středoškoláky a jejich učitele nebo začínající vědce.
Za vyhoření může i nespravedlnost v práci, říká historička kultury
Více než jedna třetina dospělých cítí většinu času únavu. A případy diagnózy vyhoření dosahují historicky nejvyšší úrovně. Co způsobuje, že se cítíme tak vyčerpaní? A jak si proti vyčerpání a vyhoření vybudovat odolnost?